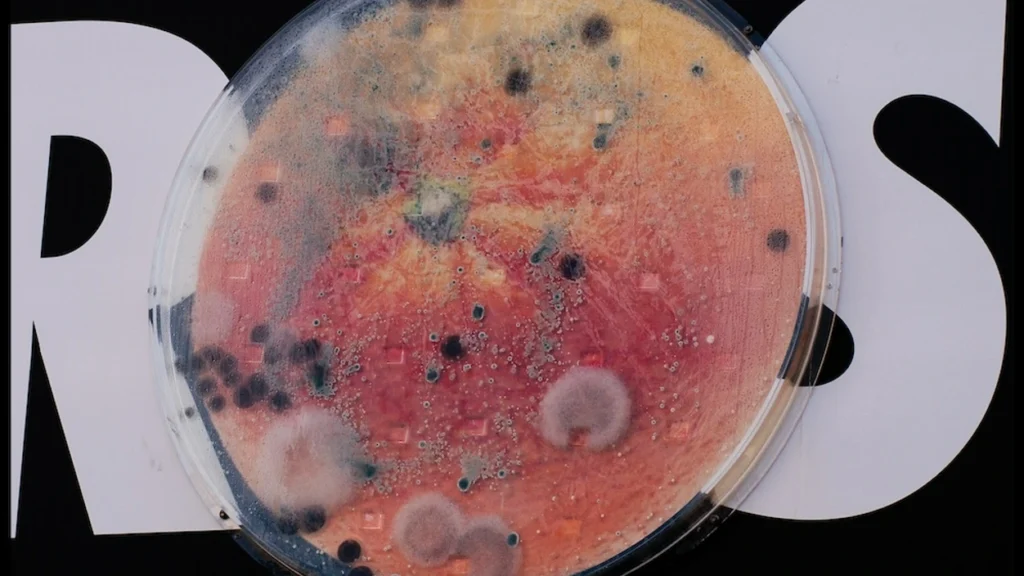

Yeni Zelanda’da yıllık 3,2 milyar dolara ulaşan gıda israfı, çevreye olduğu kadar bütçelere de zarar veriyor. 2030’a kadar hanelerde gıda israfını yarı yarıya azaltmayı hedefleyen sivil toplum kuruluşu Love Food Hate Waste (LFHW), TBWA\Yeni Zelanda ile birlikte bu konuyu küflenen açıkhava kampanyasıyla gündeme getiriyor.
Ajansın Landcare Biometrics işbirliğiyle hazırladığı çalışmada halk sağlığına zararsız küf oluşturan agarla dolu üç adet dev petri kabı oluşturuldu. Küfün gıdadan, peynirden meydana geldiği kapların çapı bir metreye ulaşıyordu. Ardından bu kaplar reklam panolarıyla buluşturuldu. Nisan ortasında başlayan kampanyada küflenme altı hafta boyunca devam etti.
Küflendikçe dikkat çeken kampanya, gıdaların bozulmadan evvel tüketilmesini hatırlatan “Önce Beni Ye” çıkartmalarına dikkat çekiyor. Yeniden kullanılabilir yapıdaki bu çıkartmalara reklam panolarındaki karekodlar aracılığıyla, LFHW internet sitesinden, bölgesel konseylerden ya da belirli Woolworth’s mağazalarından ücretsiz erişilebiliyor.
Gıda israfının, insanları aksiyon almaya yönlendirme açısından zor bir konu olduğunu, yiyecekleri çöpe gitmeden önce tüketmeyi hatırlatmanın akıllıca bir yoluna ihtiyaç duyduklarını söyleyen TBWA\Yeni Zelanda Kreatif Direktörü Shane Brandnick, “Kampanya, ekibimiz için son derece teknik bir çalışmaydı ancak yemememiz durumunda yiyeceklerin çöpe gideceğini, bunun aile bütçesi ve çevre açısından oldukça kötü bir şey olduğunu hatırlatması açısından da son derece önemliydi” diyor.
Kampanya kapsamında belirli noktalarda dev enstalasyonlar da hayata geçirildi.
LFHW Proje Yöneticisi Sophie Wolland, gıda israfının her gün akla gelen bir konu olmadığını, bu yüzden de mesajın herkesin gözünün önünde olmasına ihtiyaç duyduklarını ifade ediyor.